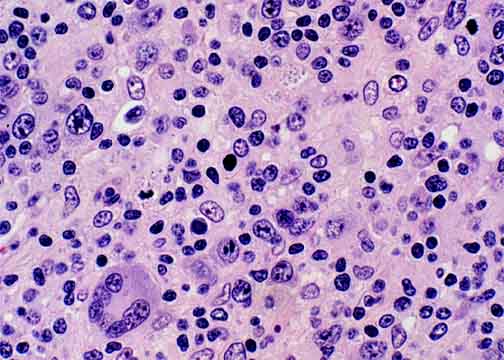

Go to:

TOC
|
Peripheral T-Cell Lymphomas: Example 5A
This lymphoma was also present in the bone marrow.
Here in a lymph node it has a mixture of small and large cells. Some of the large
cells show marked atypia including multinuclearity. Many scattered epithelioid histiocytes accompany the malignant T-cells, so that this case could be described as
Lennert's lymphoma (a designation not used in the WHO classification).

A lymph node with an infiltrate causing mostly pale, diffuse areas. The pallor
is due to the abundant cytoplasm of the T-cells and also the interspersed
epithelioid histiocytes.
|
A range of small and large atypical cells is seen here in addition to histiocytes.
|

Uh-oh, be careful! It looks like a Reed-Sternberg cell, but this isn't
Hodgkin's disease.
|
Table of Contents
|